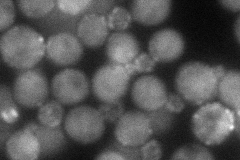

View description
Actin assembly factor, activates the Arp2/3 protein complex that nucleates branched actin filaments; localizes with the Arp2/3 complex to actin patches; homolog of the human Wiskott-Aldrich syndrome protein (WASP)
Localization:
Intensity:
Fold change:
Significance:
-
C’ GFP library in SD

below threshold16.82 -
N' NOP1pr-GFP in SD

punctate,bud neck60.6155 -
N' TEF2pr-mCherry in SD
punctate,bud neck56.3719 -
N' NATIVEpr-GFP in SD

punctate,bud neck29.0237 -
N' TEF2pr-VC and Cyto-VN in SD

cytosol31.8839 -
C’ GFP library in SD+DTT

cytosol16.810.99No -
C’ GFP library in SD+H2O2

cytosol20.331.2No -
C’ GFP library in Starvation Media

cytosol15.810.93No -
C’ GFP library on the background of Pup2-DaMP

below threshold -
C’ GFP library on the background of CCT mutant

below threshold17.37271.03206No
